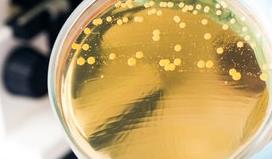
藥物敏感性檢測

注意:因業(yè)務(wù)調(diào)整,暫不接受個(gè)人委托測試,望見諒。
北檢院檢測平臺(tái)-[科研實(shí)驗(yàn)室]可提供藥物敏感性檢測服務(wù)。提供其動(dòng)物實(shí)驗(yàn)、實(shí)驗(yàn)代做、動(dòng)物喂養(yǎng)、方法學(xué)驗(yàn)證、問題診斷、效果評價(jià)等檢測,可根據(jù)相關(guān)的檢測標(biāo)準(zhǔn),提供檢測報(bào)告,在全國范圍內(nèi)使用并被認(rèn)可。
檢測范圍
他汀藥物,化療藥物,結(jié)核菌藥物,擴(kuò)散法藥物,紙片法藥物,大腸桿菌藥物,微生物藥物,致病菌藥物,抗癌藥物,抗真菌藥物,體外藥物,念珠菌感染及藥物等。
檢測項(xiàng)目
抗微生物藥物敏感性試驗(yàn),體外藥物敏感性試驗(yàn),耐碳青霉烯類銅綠假單胞菌藥物敏感性試驗(yàn),抗真菌藥物敏感性試驗(yàn),抗細(xì)菌藥物敏感性試驗(yàn),耐藥性評估等。
檢測參考標(biāo)準(zhǔn)
GB/T 27623.1-2011 漁用抗菌藥物藥效試驗(yàn)技術(shù)規(guī)范.第1部分:常量肉湯稀釋法藥物敏感性試驗(yàn)
SN/T 3384-2012 出口食品中空腸彎曲菌藥物敏感性的測定微量稀釋法
WS/T 411-2013 抗絲狀真菌藥物敏感性試驗(yàn).肉湯稀釋法
WS/T 421-2013 抗酵母樣真菌藥物敏感性試驗(yàn) 肉湯稀釋法
DB51/T 2364-2017 動(dòng)物源性細(xì)菌抗菌藥物敏感性試驗(yàn)技術(shù)規(guī)范
WS/T 639-2018 抗菌藥物敏感性試驗(yàn)的技術(shù)要求
DB21/T 2743-2017 動(dòng)物源細(xì)菌抗菌藥物敏感性檢測
WST 421-2013 抗酵母樣真菌藥物敏感性試驗(yàn) 肉湯稀釋法
DB42/T 1110-2015 牛支原體體外藥物敏感性檢測操作規(guī)程
DB15/T 2036-2020 奶牛細(xì)菌性乳房炎精準(zhǔn)治療藥物篩選技術(shù)規(guī)程
DB37/T 2806-2016 獸醫(yī)病原菌瓊脂稀釋法 藥物敏感性試驗(yàn)規(guī)范
WST 411-2013 抗絲狀真菌藥物敏感試驗(yàn)肉湯稀釋法
NY/T 4143-2022 動(dòng)物源細(xì)菌抗菌藥物敏感性測試技術(shù)規(guī)程 瓊脂稀釋法
NY/T 4144-2022 動(dòng)物源細(xì)菌抗菌藥物敏感性測試技術(shù)規(guī)程 紙片擴(kuò)散法
NY/T 4142-2022 動(dòng)物源細(xì)菌抗菌藥物敏感性測試技術(shù)規(guī)程 微量肉湯稀釋法
GB/T 27623.2-2011 漁用抗菌藥物藥效試驗(yàn)技術(shù)規(guī)范.第2部分:人工感染防治試驗(yàn)
ISO/TS 16782-2016 臨床實(shí)驗(yàn)室檢測 - 可接受的大量脫水米勒 - 瓊頓瓊脂和肉湯的抗菌藥物敏感性測試標(biāo)準(zhǔn)
WS/T 125-1999 紙片法抗菌藥物敏感試驗(yàn)標(biāo)準(zhǔn)
YY/T 0688.2-2010 臨床實(shí)驗(yàn)室檢測和體外診斷系統(tǒng) 感染病原體敏感性試驗(yàn)與抗菌劑敏感性試驗(yàn)設(shè)備的性能評價(jià) 第2部分:抗菌劑敏感性試驗(yàn)設(shè)備的性能評價(jià)
GB 26448-2010 危險(xiǎn)貨物運(yùn)輸 炸藥中間體(ANE)的敏感性試驗(yàn)方法和判據(jù)
SY/T 5358-2010 儲(chǔ)層敏感性流動(dòng)實(shí)驗(yàn)評價(jià)方法
YY/T 0688.1-2008 臨床實(shí)驗(yàn)室檢測和體外診斷系統(tǒng).感染病源體敏感性試驗(yàn)與抗菌劑敏感性試驗(yàn)設(shè)備的性能評價(jià).第1部分:抗菌劑對感染性疾病相關(guān)的快速生長需氧菌的體外活性檢測的參考方法
YB/T 4137-2013 低焊接裂紋敏感性高強(qiáng)度鋼板
GB/T 29515-2013 搪瓷用冷軋鋼板 鱗爆敏感性試驗(yàn) 氫滲透法
北檢院檢測服務(wù)流程是什么?
1、確定需求,與工程師進(jìn)行溝通,提供方案。
2、接收樣品,多渠道接收樣品(支持郵寄、上門取樣)。
3、檢測檢測,工程師進(jìn)行樣品檢測。
4、出具報(bào)告,根據(jù)樣品檢測結(jié)果,提供科學(xué)嚴(yán)謹(jǐn)?shù)膱?bào)告。
5、售后服務(wù),寄送發(fā)票及報(bào)告,跟進(jìn)后續(xù)技術(shù)支持。
北檢院檢測優(yōu)勢有哪些?
1、多個(gè)實(shí)驗(yàn)中心:實(shí)驗(yàn)室管理中心下設(shè)檢測檢測中心、科研檢測中心、X射線應(yīng)用中心。
2、面向眾多學(xué)科:面向物理、化工化學(xué)、材料、納米、環(huán)境、電子、能源等眾多學(xué)科。
3、擁有多臺(tái)精密檢測儀器。
4、從事多項(xiàng)工作:能夠從事材料微觀結(jié)構(gòu)檢測、定性和定暨檢測、材料性能檢測、材料質(zhì)量綜合評定等工作。
5、全天化服務(wù)時(shí)間:提供24小時(shí)開放服務(wù)、網(wǎng)絡(luò)化管理。
6、機(jī)構(gòu)檢測能力:具備向校內(nèi)外科學(xué)研究和品質(zhì)鑒定提供公正、科研檢測數(shù)據(jù)能力的重要機(jī)構(gòu)。
以上就是關(guān)于藥物敏感性檢測的相關(guān)內(nèi)容,更多檢測需求,你可聯(lián)系我們在線實(shí)驗(yàn)室工程師,為您詳細(xì)洽談實(shí)驗(yàn)周期及流程問題!
檢測流程
1、收到客戶的檢測需求委托。
2、確立檢測目標(biāo)和檢測需求
3、所在實(shí)驗(yàn)室檢測工程師進(jìn)行報(bào)價(jià)。
4、客戶前期寄樣,將樣品寄送到相關(guān)實(shí)驗(yàn)室。
5、工程師對樣品進(jìn)行樣品初檢、入庫以及編號(hào)處理。
6、確認(rèn)檢測需求,簽定保密協(xié)議書,保護(hù)客戶隱私。
7、成立對應(yīng)檢測小組,為客戶安排檢測項(xiàng)目及試驗(yàn)。
8、7-15個(gè)工作日完成試驗(yàn),具體日期請依據(jù)工程師提供的日期為準(zhǔn)。
9、工程師整理檢測結(jié)果和數(shù)據(jù),出具檢測報(bào)告書。
10、將報(bào)告以郵遞、傳真、電子郵件等方式送至客戶手中。
檢測實(shí)驗(yàn)室(部分)




檢測優(yōu)勢
1、綜合性檢測技術(shù)研究院等多項(xiàng)榮譽(yù)證書。
2、檢測數(shù)據(jù)庫知識(shí)儲(chǔ)備大,檢測經(jīng)驗(yàn)豐富。
3、檢測周期短,檢測費(fèi)用低。
4、可依據(jù)客戶需求定制試驗(yàn)計(jì)劃。
5、檢測設(shè)備齊全,實(shí)驗(yàn)室體系完整
6、檢測工程師專業(yè)知識(shí)過硬,檢測經(jīng)驗(yàn)豐富。
7、可以運(yùn)用36種語言編寫MSDS報(bào)告服務(wù)。
8、多家實(shí)驗(yàn)室分支,支持上門取樣或寄樣檢測服務(wù)。
結(jié)語
以上是關(guān)于藥物敏感性檢測的檢測服務(wù)介紹,僅展示了部分檢測樣品和檢測項(xiàng)目,如有其它需求或疑問請咨詢在線工程師。







